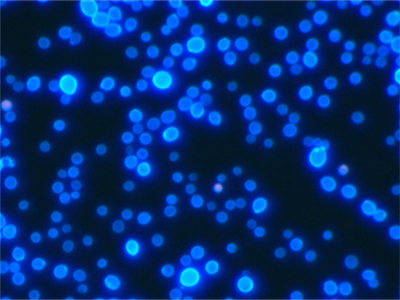
荧光真菌

正置荧光显微镜UB203i-FL采用无限远平场消色差物镜和大视野目镜,可用双目或三目观察,搭配LED荧光激发装置,实现明场和荧光显微观察,荧光附件可以根据客户要求进行搭配,通过拉杆或者转盘即可轻松实现明场和荧光观察方式之间的切换,LED落射荧光照明系统(B/G/U单、双、三色可选)。同时还可以通过接口适配器连接相机实现显微成像的目的,可搭载630-2000万像素超高分辨率摄像头(也可升级更高级别摄像头),实时观测拍摄镜下图像,进行后期分析处理,能够从不同的角度和维度来观察和分析真菌,从而获得更全面的信息,广泛应用于医院检验科临床诊断、皮肤真菌检测、生物实验室、真菌细菌、细胞观察等。
正置荧光显微镜UB203i-FL采用无限远平场消色差物镜和大视野目镜,可用双目或三目观察,搭配LED荧光激发装置,实现明场和荧光显微观察,荧光附件可以根据客户要求进行搭配,通过拉杆或者转盘即可轻松实现明场和荧光观察方式之间的切换,LED落射荧光照明系统(B/G/U单、双、三色可选)。同时还可以通过接口适配器连接相机实现显微成像的目的,可搭载630-2000万像素超高分辨率摄像头(也可升级更高级别摄像头),实时观测拍摄镜下图像,进行后期分析处理,能够从不同的角度和维度来观察和分析真菌,从而获得更全面的信息,广泛应用于医院检验科临床诊断、生物实验室、细菌、细胞观察等。
| 光学系统 | 无限远色差独立校正光学系统 | |
照明系统 | 内置投射照明系统 | |
柯勒照明(视场光阑可调) | ||
LED功耗 3W(标称),预对中 | ||
调焦机构 | 载物台高度调节(粗调:20mm) | |
粗调旋转每转:30mm,聚焦限位钮 | ||
粗调焦旋钮的张力可调节 | ||
细调焦旋钮(最小可调幅度:1μm) | ||
物镜转盘 | 固定四孔,向内旋转 | |
载物台 | 机械固定载物台:156mm(L) x 138mm(W) | |
移动范围:X=76mm, Y=54mm | ||
具有样品位置刻度 | ||
| 载物台XY移动可锁定 | ||
观察筒 | 30°倾斜三目观察筒 | |
光路选择:目镜/相机口=80/20 | ||
| 瞳距调节范围:52-75mm | ||
| 目镜 | 高眼点平场 | |
·10X 视场数(FN)20 | ||
·10X 视场数(FN)22(可选) | ||
·16X 视场数(FN)13(可选) | ||
聚光镜 | 阿贝聚光镜NA 1.25(油浸时) | |
内置孔径光阑 | ||
物镜 | 平场消色差物镜(标配) | |
·4X NA 0.13 W.D. 21.5mm | ||
·10X NA 0.25 W.D. 7.5mm | ||
·20X NA 0.4 W.D. 4.9mm(可选) | ||
·40X NA 0.65 W.D. 0.65mm | ||
·100X NA 1.25 W.D. 0.185mm | ||
LED落射荧光照明系统 | LED冷光源,亮度连续可调,可配置三种激发块。(B/G/U单、双、三色可选) | |
UV紫外激发组DAPI:360nm/50nm;400nm;410nmLP | ||
B蓝色激发组FITC:475nm/35nm;500nm;515nmLP | ||
G绿色激发组TRITC:530nm/40nm;560nm;575nmLP | ||
观察方法 | 明场、荧光(可选) | |
额定电压/电流 | 外置式电源适配器,输入100V-240V-AC50/60HZ,输出DC12V2A | |
能耗 | 3W | |
成像端口 | C型接口 | ·TV1XC-U |
·TV0.65XC-U(选配) | ||
·TV0.5XC-U(选配) | ||
| 显微镜摄像头 | USB2.0 | MHD500 |
| USB3.0 | MHC600、MHD600、MHD800、MHD1200、MHD2000、MHS500、MHS900、MHS2100 | |

热线020-87096762

致电13418179239